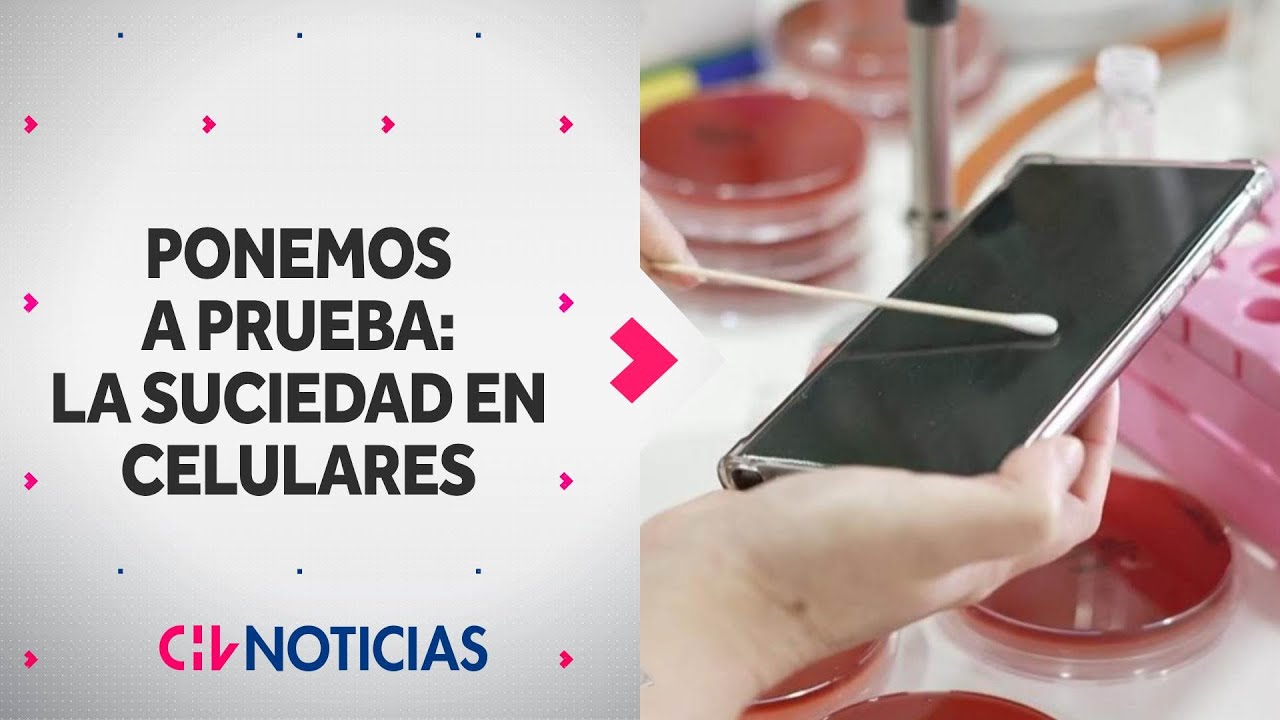
PONEMOS A PRUEBA: &iquest;Qu&eacute; tanta suciedad acumulan los celulares? Estos son los resultados -CHV Noticias

Видео с ютуба Suciedad

Andrés Calamaro - Alta suciedad. Made in Argentina. Directo 2005

Alta suciedad

Carla Morrison - Suciedad (letra)

Historia de la higiene y la suciedad humana | Minidocumental

Suciedad

Alta suciedad – Acru y Emiliano Brancciari | Sesiones ¡FA!

2- "SUCIEDAD" - 7DB (VIDEOCLIP HD) 2025

Suciedad (feat. Soriano)

Alta Suciedad - Andrés Calamaro

"DESORDEN, SUCIEDAD Y EXCLUIDOS" ¿Qué nos muestran? #constelacionesfamiliares. INSCONSFA

Enfermedades ocasionadas por la suciedad (VIDEO EDUCATIVO)
PONEMOS A PRUEBA: ¿Qué tanta suciedad acumulan los celulares? Estos son los resultados -CHV Noticias

SUCIEDAD - VIOLENCIA (SUDOR DE HUEVOS Cover) | feat. Christian Vandenberg | Guatemala

¡La limpieza gratuita más peligrosa de la historia! 💀

Atrapado en el barro | Suciedad | Bluey Español Canal Oficial

Con Cif Expert Baño decile chau a la suciedad 👋

5 AÑOS DE SUCIEDAD 😱 ¿Imposible de limpiar?

Arbol - Alta suciedad

Alta Suciedad | Tráiler Oficial | Carajo

El Robo del Siglo (2020) - Clip "Alta Suciedad"